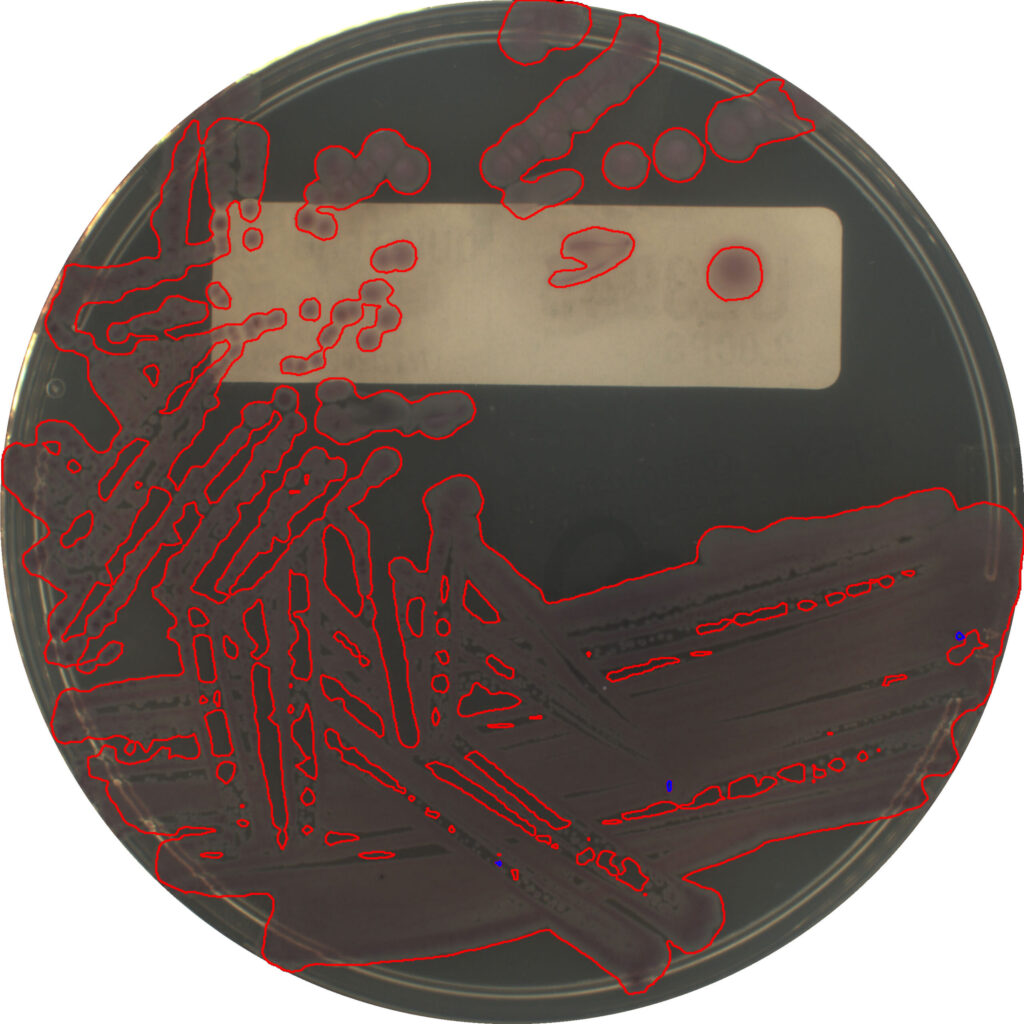

Increases the efficiency of AIPLAK by incorporating Sener’s AI algorithms: early growth detection (continuous monitoring), discrimination between samples with and without growth, colony counting advice, as well as contamination…
New dual protocol technology revolutionises clinical labs,
offering easy operation and significant value, potentially transforming daily workflows

The intelligent incubation system is the only system on the market equipped with 2 complementary imaging systems. A first continuous monitoring system that allows uninterrupted monitoring of sample growth, being capable of generating alarms as soon as growth is detected in the sample. The second system captures the overhead image, digitalising the sample and executing artificial intelligence algorithms to determine the characteristics of that growth. This advanced platform that combines time-based and growth-based management protocols, provides the laboratory with a unique tool to address emergency situations, to efficiently optimise workflow processes thus contributing to a more effective operation and accelerated results in the laboratory.

AI-based algorithm designed to classify urine samples based on microbial growth, distinguishing between those that show bacterial growth and those that do not. The algorithm aims to streamline laboratory workflows, allowing technicians to make faster and more accurate decisions regarding sample processing and analysis.

A suite of algorithms applied on the continuous monitoring images to generated alarms based on real growth according to Lab configuration.
Continuous monitoring tech detects microorganism growth earlier than microbiologists, optimising diagnosis time, enabling rapid MRSA isolation, and preventing nosocomial infections.

Contact us
Unlock Precision in Bacteriological Digitalisation with AI Modules: Continuous Monitoring, Intelligent Interpretation, Growth Detection, and More!